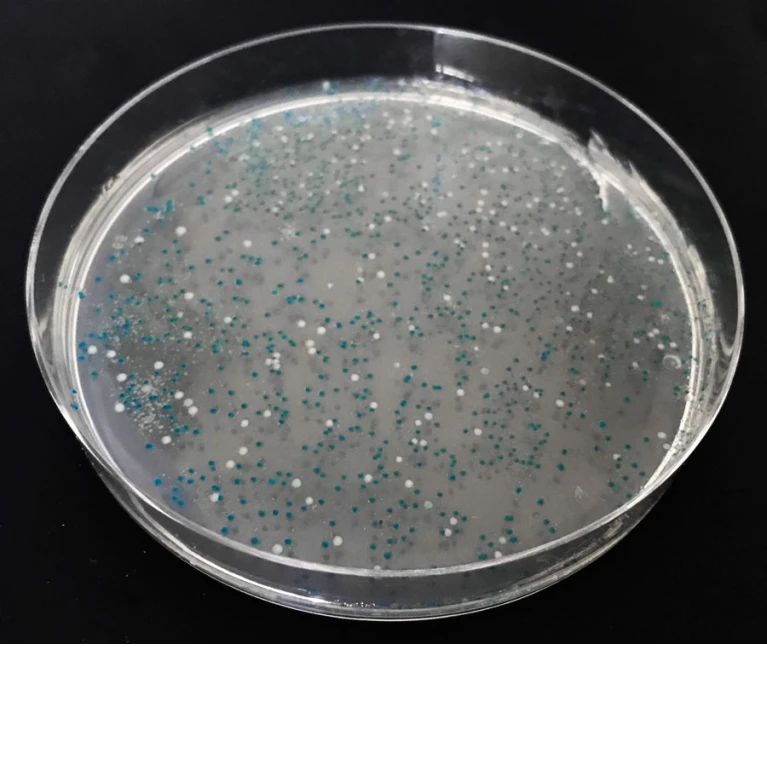
JO-FI™ komórki kompetentne JO-FI™ komórki kompetentne

Pokazuje 1 do 7 z 7 (1 Stron)
JO-FI™ komórki kompetentne
Wysokowydajny szczep do każdego rodzaju klonowania i standardowej transformacji plazmidowym DNA. Stabilna replikacja plazmidów wysokokopijnych.
| Numer katalogowy | Wielkość | Cena netto | Ilość | ||
|---|---|---|---|---|---|
| 1033-20 | 20 szt. |
| Instrukcja | MSDS | |
| 1033-40 | 40 szt. |
|
Liga5™
5-minutowy zestaw do ligacji DNA o końcach tępych i lepkich.
| Numer katalogowy | Wielkość | Cena netto | Ilość | ||
|---|---|---|---|---|---|
| 1108-25 | 25 reakcji |
| Instrukcja | MSDS | |
| 1108-50 | 50 reakcji |
| |||
| 1108-150 | 150 reakcji |
|
E.coli Transformer Express Kit
Zestaw do przygotowania i transformacji komórek kompetentnych E.coli. Metoda chemiczna pozwalająca na transformację w 1 minutę, bez szoku cieplnego.
| Numer katalogowy | Wielkość | Cena netto | Ilość | ||
|---|---|---|---|---|---|
| 4020-240E | 6 x 40 reakcji |
| Instrukcja | MSDS |
E.coli Transformer Kit
Zestaw do przygotowania i transformacji komórek kompetentnych E.coli. Metoda chemiczna.
| Numer katalogowy | Wielkość | Cena netto | Ilość | ||
|---|---|---|---|---|---|
| 4020-240 | 6 x 40 reakcji |
| Instrukcja | MSDS |
OverLap™ Assembly Cloning Kit
Zestaw do szybkiego klonowania produktów PCR bez użycia ligazy DNA. Oparty na metodzie Gibsona.
| Numer katalogowy | Wielkość | Cena netto | Ilość | ||
|---|---|---|---|---|---|
| 1024-10 | 10 reakcji |
| Instrukcja | MSDS | |
| 1024-50 | 50 reakcji |
|
T4 ligaza DNA
Enzym umożliwiający łączenie pęknięć w pojedynczych łańcuchach wchodzących w skład dsDNA. Forma: roztwór o stężeniu 1 U/µl
| Numer katalogowy | Wielkość | Cena netto | Ilość | ||
|---|---|---|---|---|---|
| 1004-200 | 200 U |
| Instrukcja | MSDS | |
| 1004-1000 | 1000 U |
|
Thermo PNK
Termostabilna kinaza polinukleotydowa. Forma: roztwór o stężeniu 10 U/µl.
| Numer katalogowy | Wielkość | |
|---|---|---|
| 1016-50 | 500 U | Na zamówienie. Napisz do nas: orders@aabiot.com |